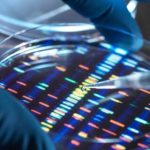

Post Views: 179+ 139 Samsung njoftoi Exynos 2600 javën e kaluar si çipseti i parë 2nm në botë. Pritet të debutojë në serinë Galaxy S26 […]
Presidenti ukrainas konfirmon bisedimet me Trumpin për vendosjen e mundshme të trupave amerikane në Ukrainë
Post Views: 179+ 149 Presidenti ukrainas Volodymyr Zelensky ka konfirmuar se po zhvillon bisedime me presidentin e SHBA-së, Donald Trump mbi vendosjen e mundshme të […]
NTP-Shkup: Gjatë festave do të ketë reduktim të orareve të qarkullimit të autobusëve
Post Views: 179+ 124 NTP Shkup do të ketë një regjim të modifikuar të trafikut të transportit publik gjatë festave të Vitit të Ri, si […]
Një ilaç kundër dhimbjeve që përdoret gjerësisht mund të sjellë më shumë dëm sesa dobi
Post Views: 179+ 105 Studimi i ri shkencor analizon efektet reale, rreziqet e fshehura dhe arsyen pse përfitimi shpesh mbetet minimal Tramadoli, një nga barnat […]
MEPSO vë në funksion linjën e re 110 kV, rritet siguria dhe kapaciteti i rrjetit elektroenergjetik në rajon
Post Views: 179+ 138 MEPSO ka vënë në funksion linjën e rindërtuar të transmetimit 110 kilovolt, numër 109, në relacionin TS Manastir 1 – TS […]
Bekim Sali emërohet zëvendëskryeministër i parë
Post Views: 179+ 140 Në seancën e sotme të Qeverisë, Bekim Sali nga koalicioni VLEN është emëruar zëvendëskryeministër i parë. Sali në rrjetin social Facebook […]
Prodhimi industrial në Maqedoni deri në nëntor u rrit për 1,9 për qind, krahasuar me vitin e kaluar
Post Views: 179+ 123 Prodhimi industrial në periudhën janar-nëntor të vitit 2025, në krahasim me të njejtën periudhë të vitit të kaluar shënon rritje prej […]
Qeveria miratoi Propozim-Ligjin për Prokurorinë Publike
Post Views: 179+ 103 Qeveria e Maqedonisë së Veriut, miratoi Propozim-Ligjin për Prokurorinë Publike, i cili prezantohet si pjesë kyçe e agjendës reformuese për sundimin […]
Për shkak të një aksidenti ndërpritet qarkullimi i automjeteve për në vendkalimin kufitar Qafë Thanë
Post Views: 179+ 66 Lidhja Auto-Moto e Maqedonisë njofton se për shkak të një aksidenti trafiku në rrugën për në vendkalimin kufitar Qafë Thanë është […]
Moti sot në Maqedoninë e Veriut
Post Views: 179+ 113 Moti sot në Maqedoninë e Veriut do të jetë me diell dhe vranësira. Në vend do të fryjë një erë e […]